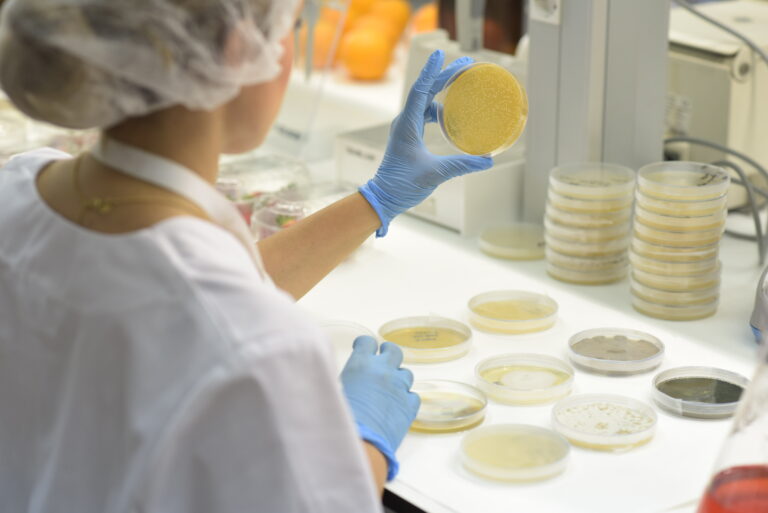

eficiencia hídrica
Un estudio de TRICHODEX y la Universidad de Lisboa demuestra que los bioestimulantes microbianos ayudan a plántulas de maíz y tomate a crecer más fuertes y resistir la sequía desde sus primeras etapas de desarrollo, ofreciendo soluciones prácticas para una agricultura más sostenible.
El encuentro Green Gateway – Climate Finance in Action reunió a banca europea y expertos del sector agroalimentario para debatir cómo canalizar fondos climáticos hacia el campo.
Carmen Crespo resalta la labor de las entidades beneficiarias de las ayudas en el desarrollo de iniciativas que aportan a la eficiencia hídrica.
Giropoma afronta una nueva campaña caracterizada por la falta de volumen de algunas variedades de manzana, especialmente la Golden y una menor disponibilidad hídrica.
LO ÚLTIMO
La campaña de berries en Huelva afronta un curso que debe analizarse con el foco muy abierto, más allá de la dificultad coyuntural, debe situarse en un escenario estructural de resistencia.
Los resultados mejoran para todos los socios europeos, mientras que en el hemisferio sur comienza una temporada prometedora: en Australia, las ventas y la comunicación con el consumidor ya están en marcha; Chile y Argentina avanzan en el desarrollo de los volúmenes comerciales; Sudáfrica se centra en el reconocimiento de marca; y en Nueva Zelanda continúan las fases de prueba.
Artículo de José Carlos Gómez, Director Comercial de El Dulze
ÚLTIMA REVISTA
¿Quieres enterarte de todo?
¡Suscríbete a la revista!
Entérate de cada detalle del sector y conocer la opinión de los mejores expertos. Rellena el siguiente formulario para suscribirte y empieza a recibir la revista donde tú decidas.